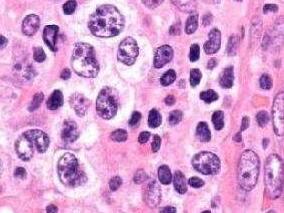
来那度胺治疗成人T细胞淋巴瘤恶化或复发前景喜人

-
老年套细胞淋巴瘤患者:RBAC500方案可行吗?
环球医学资讯
2017年03月28日
点击量:1836
1小时条评论2017年1月,发表在《Lancet Haematol》的一项由意大利科学家进行的多中心II期试验比较了老年套细胞淋巴瘤中,利妥昔单抗、苯达莫司汀和低剂量阿糖胞苷诱导治疗的有效性和安全性。 背景:在套细胞淋巴瘤的先导试验中,利妥昔单抗、苯达莫司汀和阿糖胞苷联合(R-BAC)...
-
非雄那胺预防前列腺癌有何获益?
环球医学资讯
2017年03月24日
点击量:500
1小时条评论前列腺癌是美国男性中最常见的癌症。2016年8月,发表在《J Natl Cancer Inst》的一项由美国科学家进行的研究比较了前列腺癌预防试验中,非那雄胺和安慰剂的长期结局。 背景:非那雄胺已被发现能减少低级前列腺癌风险,但对总生存期没有影响。非那雄胺的长期不良和有...
-
害怕黑色素瘤复发?心理教育大显身手
环球医学资讯
2017年03月24日
点击量:221
1小时条评论黑色素瘤患者,尤其是黑色素瘤高风险患者的临床随访,对于早期检测疾病、复发或进展、确定治疗相关发病率和提供心理服务很重要。2016年12月发表在《J Clin Oncol》的一项随机对照试验考察了患另一原发性黑色素瘤高风险的患者中,心理教育减少黑色素瘤复发恐惧的有效...
-
新确诊头颈部癌症患者:恶病质患病率高
环球医学资讯
2017年03月23日
点击量:231
1小时条评论癌症患者中,体重减轻与单纯饥饿、扰乱代谢或两者相关。头颈部癌症(HNC)患者中,体重减轻常归因于单纯饥饿,这是由于已知明显的口腔症状可阻碍膳食摄入。该人群中,恶病质仍然是一个相对未探讨的现象。2017年3月,发表在《Nutrition.》的一项探索性研究探讨了新确...
-
肥胖是硬伤!男性癌症幸存者要注意
环球医学资讯
2017年03月21日
点击量:391
1小时条评论2016年12月,发表在《J Clin Oncol》的一项由韩国科学家进行的研究考察了男性癌症幸存者确诊前体质指数对第二次原发癌风险的影响。 目的:男性癌症幸存者比普通人群有着更高的癌症风险,该风险或由肥胖或肥胖相关致癌易感性增加所致。研究者评价了第一次癌症确诊前...
-
来那度胺治疗成人T细胞淋巴瘤恶化或复发前景喜人
环球医学资讯
2017年03月21日
点击量:939
1小时条评论T细胞淋巴瘤是罕见的非霍奇金淋巴瘤。2016年12月,发表在《J Clin Oncol》的一项由日本科学家进行的研究考察了来那度胺治疗成人T细胞淋巴瘤恶化或复发的安全性和有效性。 目的:T-细胞白血病/淋巴瘤(ATL)的治疗选择较少,预后较差。一项关于来那度胺的I期研究在AT...
-
肥胖或影响癌症患者化疗疗效
环球医学资讯
2017年03月21日
点击量:389
1小时条评论2016年12月,发表在《J Clin Oncol》的一篇文章介绍了癌症患者的肥胖管理。 目的:肥胖(体质指数[BMI]ge;30 kg/m2)在癌症患者中较为常见。研究人员评价了癌症肥胖患者的管理问题,重点针对肥胖如何影响治疗选择(包括化疗剂量),如何影响化疗毒性和手术并发症,...
-
硒补充剂能否预防结直肠腺瘤?
环球医学资讯
2017年03月20日
点击量:333
1小时条评论硒补充剂或有助于预防结直肠癌;结直肠腺瘤作为结直肠癌的前体,是结直肠癌的替代。硒补充剂或可增加2型糖尿病(T2D)的风险。2016年8月,发表在《J Natl Cancer Inst.》的一项研究调查了硒补充剂预防结直肠腺瘤的疗效及2型糖尿病相关风险。 硒和赛来昔布(Sel/Cel...
-
减重是否改善女性癌症患者生存?
环球医学资讯
2017年03月20日
点击量:239
1小时条评论观察性试验证据显示,超重/肥胖与女性乳腺癌和一些其他癌症患者生存期缩短相关。尽管针对以癌症终点的全面的、明确的减重辅助干预试验有待开展,但已经有大量随机对照试验评价了女性癌症幸存者的减重干预。2016年12月,发表在《J Clin Oncol.》的一项研究评价了乳腺...
-
肿瘤RCT的设计 真正关注临床了吗?
环球医学资讯
2017年03月20日
点击量:542
1小时条评论设计优良的随机对照试验(RCTs)可以防止治疗比较中的偏倚,并为临床实践的改变提供有力支持。但是,许多RCTs的设计和报告能给予临床实践的相关性少之又少。2016年12月,发表在《Lancet Oncol》的一篇文章调查了肿瘤RCT与临床的关联性。 在这项个人观点中,研究者讨...

会员登录

